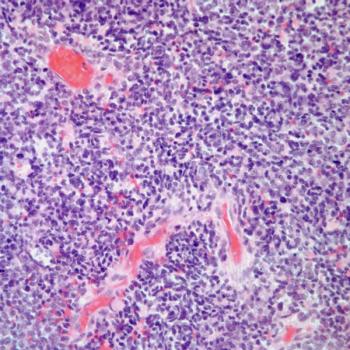

Endometrial Cancer
Latest News
Latest Videos

CME Content
More News

SEER data showed that Black patients endometrioid endometrial carcinoma had higher 5-year cancer-related death rates compared with their White counterparts.

The survival benefit with dostarlimab/chemotherapy was deemed unprecedented in patients with microsatellite instability high primary advanced or recurrent endometrial cancer.

Results from the KEYNOTE-868 trial showed a favorable benefit of pembrolizumab plus chemotherapy across endometrial cancer subgroups.

Data from the phase 3 RUBY trial support the recommendation for dostarlimab plus chemotherapy for patients with advanced MSI-H/dMMR endometrial cancer.

Data from the phase 3 NRG-GY018 trial support the supplemental biologics license application for pembrolizumab plus chemotherapy as a treatment for those with primary advanced or recurrent endometrial cancer.

Data from part 2 of the phase 3 RUBY trial support the use of dostarlimab as a backbone for immunotherapy-based combinations in patients with primary advanced or recurrent endometrial cancer.

Pembrolizumab combined with carboplatin and paclitaxel resulted in response rates in patients with recurrent endometrial cancer.

The European approval for dostarlimab and chemotherapy for dMMR/MSI-H, primary advanced or recurrent endometrial cancer is based on data from part 1 of the phase 3 RUBY/ENGOT-EN6/GOG3031/NSGO trial.

The phase 3 NRG GY018 trial added immunotherapy to chemotherapy in patients with recurrent endometrial cancer, regardless of mismatch repair deficient or proficient disease status, according to Ramez N. Eskander, MD.

Total costs for endometrial cancer therapy in the first line appear to be higher for those diagnosed with metastatic disease compared with those who do not have metastatic disease.

Significant progression-free survival was seen in those with TP53 wild-type advanced/recurrent endometrial cancer who were treated with maintenance selinexor.

Investigators report a trend in overall survival improvement among patients with advanced/recurrent endometrial cancer treated with atezolizumab and chemotherapy.

Future analyses will look at durvalumab/olaparib for endometrial cancer populations with TP53 and POLE alterations, as well as those with estrogen receptor and progesterone receptor positivity.

Patients with mismatch repair proficient, newly diagnosed, advanced or recurrent endometrial cancer may have enhanced benefit with the addition of olaparib to durvalumab.

The progression-free survival benefit of dostarlimab and chemotherapy extends to those with mismatch repair deficient or microsatellite instability–high advanced endometrial cancer.

Investigators report that loss of MMR mechanism is not predictive of response to chemotherapy or pembrolizumab in patients with stage III or IVA, stage IVB, or recurrent endometrial cancer.

Durvalumab plus olaparib, durvalumab monotherapy, or chemotherapy plus durvalumab saw an improvement in progression-free survival for patients with newly diagnosed advanced or recurrent endometrial cancer.
Treatment with dostarlimab plus chemotherapy followed by dostarlimab appears to improve outcomes among patients with advanced endometrial cancer and mismatch repair deficient disease in the phase 3 RUBY trial.

Data from the phase 3 RUBY/ENGOT-EN6/GOG3031/NSGO trial support the use of frontline dostarlimab plus chemotherapy for dMMR/MSI-H primary advanced or recurrent endometrial cancer.

Data from the phase 3 KEYNOTE-775 trial support lenvatinib plus pembrolizumab as a standard therapy option for patients with previously treated advanced endometrial cancer.

Data from the phase 3 RUBY trial may support the use of dostarlimab plus chemotherapy as a new standard of care in patients with newly diagnosed primary advanced or recurrent endometrial carcinoma.

Shannon N. Westin, MD, MPH, FACOG, presented results showing a progression-free survival response with combination durvalumab plus olaparib in newly diagnosed advanced or recurrent endometrial cancer.

Atezolizumab plus platinum chemotherapy showed significant improvement in progression-free survival for patients with frontline advanced or recurrent endometrial carcinoma.

Findings from a secondary data analysis suggest a need for further research to determine risk factors that place younger patients who are Puerto Rican at a high risk of endometrial cancer.

Findings from a meta-analysis support the feasibility of administering hysteroscopic surgery plus progesterone to patients of childbearing age with various types of endometrial cancer.

























































































